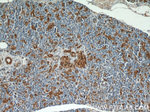
ENO1 Antibody in Immunohistochemistry (Paraffin) (IHC (P))

Search
Proteintech
ENO1 Polyclonal Antibody
{{$productOrderCtrl.translations['antibody.pdp.commerceCard.promotion.promotions']}}
{{$productOrderCtrl.translations['antibody.pdp.commerceCard.promotion.viewpromo']}}
{{$productOrderCtrl.translations['antibody.pdp.commerceCard.promotion.promocode']}}: {{promo.promoCode}} {{promo.promoTitle}} {{promo.promoDescription}}. {{$productOrderCtrl.translations['antibody.pdp.commerceCard.promotion.learnmore']}}
产品信息
55237-1-AP
种属反应
宿主/亚型
分类
类型
抗原
偶联物
形式
浓度
规格
纯化类型
保存液
内含物
保存条件
运输条件
产品详细信息
This antibody is specific to ENO1. It has no cross reaction to ENO2 and ENO3.
靶标信息
Enolase (2-phosphogly-cerate hydrolyase or phosphopyruvate hydrates) is a glycolytic enzyme that catalyzes the dehydration and conversion of 2-phosphoglycerate to phosphoenolpyruvate. It comprises three distinct subunits, alpha, beta and gamma. Non Neuronal Enolase(ENO1) is an isoform of mammalian enolase and is composed of 2 alpha subunits. The gene for ENO1 also encodes a shorter monomeric structural lens protein, tau-crystallin. Multifunctional enzyme that, as well as its role in glycolysis, plays a part in various processes such as growth control, hypoxia tolerance and allergic responses. May also function in the intravascular and pericellular fibrinolytic system due to its ability to serve as a receptor and activator of plasminogen on the cell surface of several cell-types such as leukocytes and neurons. Stimulates immunoglobulin production.Used as a diagnostic marker for many tumors and, in the heterodimeric form, alpha/gamma, as a marker for hypoxic brain injury after cardiac arrest. Also marker for endometriosis. Antibodies against alpha-enolase are present in sera from patients with cancer-associated retinopathy syndrome (CAR), a progressive blinding disease which occurs in the presence of systemic tumor growth, primarily small-cell carcinoma of the lung and other malignancies. Is identified as an autoantigen in Hashimoto encephalopathy (HE) a rare autoimmune disease associated with Hashimoto thyroiditis (HT). HT is a disorder in which destructive processes overcome the potential capacity of thyroid replacement leading to hypothyroidism.
仅用于科研。不用于诊断过程。未经明确授权不得转售。
生物信息学
蛋白别名: 2-phospho-D-glycerate hydro-lyase; 2-phospho-D-glycerate hydrolase; alpha enolase; alpha enolase (EC 4.2.1.11); alpha enolase like 1; Alpha-enolase; c-Myc promoter binding protein; C-myc promoter-binding protein; ENO1 intronic transcript 1; ENO1 intronic transcript 1 (non-protein coding); enoa; Enolase 1; enolase 1, (alpha); enolase 1, alpha non-neuron; enolase-alpha; epididymis secretory protein Li 17; MBP-1; MPB-1; MYC promoter-binding protein 1; NNE; Non-neural enolase; Phosphopyruvate hydratase; Plasminogen-binding protein; tau-crystallin; transcription factor; unnamed protein product
基因别名: 0610008I15; AL022784; Eno-1; ENO1; ENO1-IT1; ENO1L1; HEL-S-17; MBP-1; MBPB1; MPB1; NNE; PPH
UniProt ID: (Human) P06733, (Mouse) P17182, (Rat) P04764
Entrez Gene ID: (Human) 2023, (Mouse) 13806, (Rat) 24333